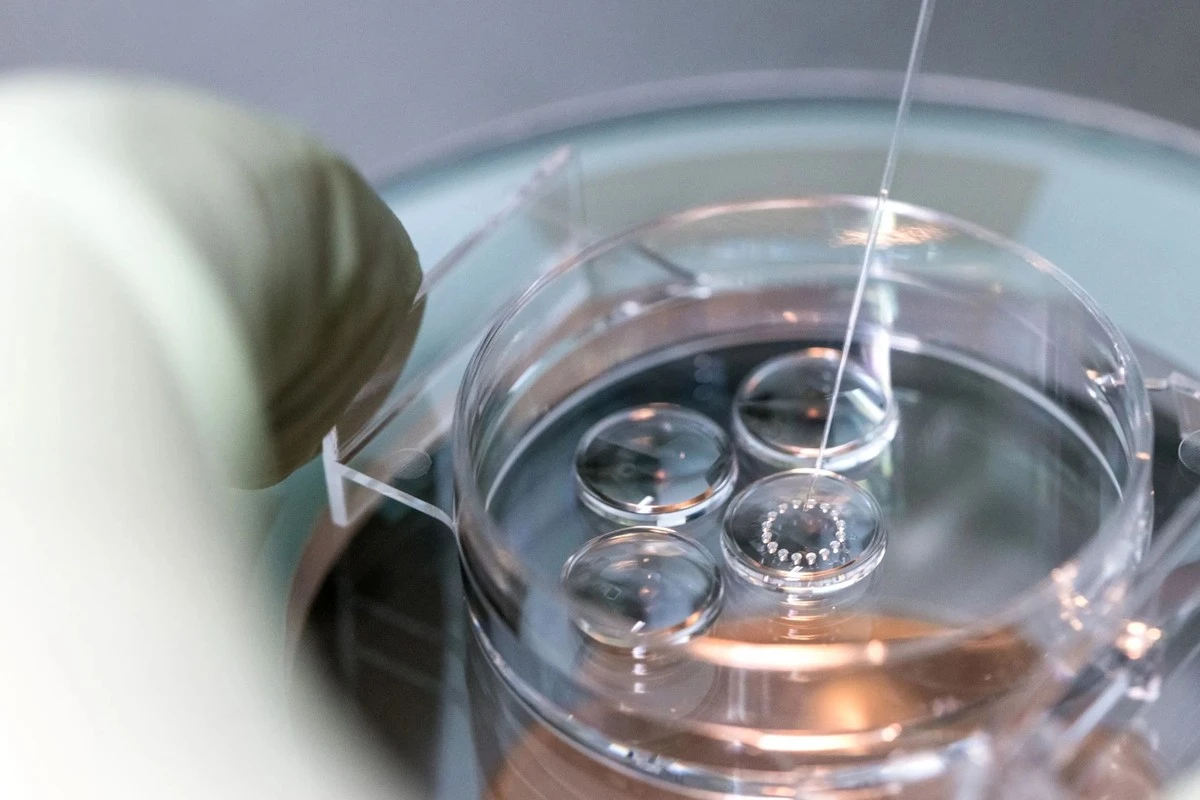
Proč se ženy po IVF nemusí bát rakoviny víc než ostatní - image 1

Desítky let nás provázela nejistota a tichý strach: může umělé oplodnění spustit bujení buněk? Pro tisíce párů, které v Česku každoročně podstupují IVF, je to otázka, která visí ve vzduchu v každé čekárně reprodukční kliniky. Konečně máme v rukou data od statisíců žen, která přinášejí nečekaně uklidňující, ale i velmi specifické odpovědi.
Data, která mluví jasně: Žádná katastrofa se nekoná
Vědci sledovali rekordních 417 000 žen po dobu deseti let. Výsledek? Celkové riziko rakoviny u žen po umělém oplodnění je prakticky stejné jako u zbytku populace. Pokud jste tedy měla obavy, že hormonální stimulace je přímou jízdenkou k onkologické diagnóze, můžete si vydechnout.
V mé praxi se často setkávám s tím, že se lidé soustředí na děsivé titulky, ale realita je mnohem jemnější. Tady je to, co studie skutečně ukázala:
- IVF s odběrem vajíček: Celkové riziko je srovnatelné s běžnou populací.
- Lék Clomid: Tady byla zaznamenána mírná odchylka (asi 8 případů navíc na 100 000 žen ročně).
- Překvapivý bonus: Ženy po IVF mají paradoxně nižší výskyt rakoviny plic a děložního čípku.
Proč se u některých typů čísla liší?
Ale pozor, je tu onen „háček“. U melanomu a rakoviny vaječníků byla čísla o něco vyšší. Znamená to, že za to může IVF? Pravděpodobně ne. Tady vstupuje do hry logika, kterou mnoho lidí přehlíží. Ženy podstupující IVF mají specifický životní styl:
Zajímavé články:
Představte si to jako filtr. Ženy, které jdou na kliniku, jsou pod neustálým dohledem lékařů. Častěji chodí na preventivní prohlídky a v Česku, kde je úroveň screeningu vysoká, se prostě více věcí najde včas. Navíc diagnozy jako endometrióza, které k neplodnosti vedou, samy o sobě mírně zvyšují riziko určitých typů nádorů bez ohledu na léčbu.
Co s tím můžete dělat právě teď?
Pokud plánujete rodinu s pomocí medicíny nebo už máte proces za sebou, tady jsou tři kroky, které jsou důležitější než stres z tabulek:
- Nepodceňujte pihy: Jelikož studie ukázala vyšší výskyt melanomu, objednejte se na kontrolu znamének. Je to jednoduchý krok, který zachraňuje životy.
- Sledujte své tělo, ne statistiky: Pokud jste v minulosti brala Clomid (clomifen citrát), zmiňte to svému gynekologovi při běžné kontrole.
- Screening je váš přítel: Nižší výskyt rakoviny děložního čípku u IVF skupiny je přisuzován právě tomu, že tyto ženy „neutíkají“ z preventivních prohlídek. Buďte jednou z nich.
Mimochodem, věděli jste, že rizika spojená s IVF jsou v absolutních číslech srovnatelná s riziky běžné antikoncepční pilulky? Je to fascinující ukázka toho, jak vnímáme nebezpečí selektivně.
Jaký je váš názor na rovnováhu mezi touhou po dítěti a zdravotními riziky? Máte pocit, že jsou pacienti v českých centrech asistované reprodukce o těchto věcech dostatečně informováni?









